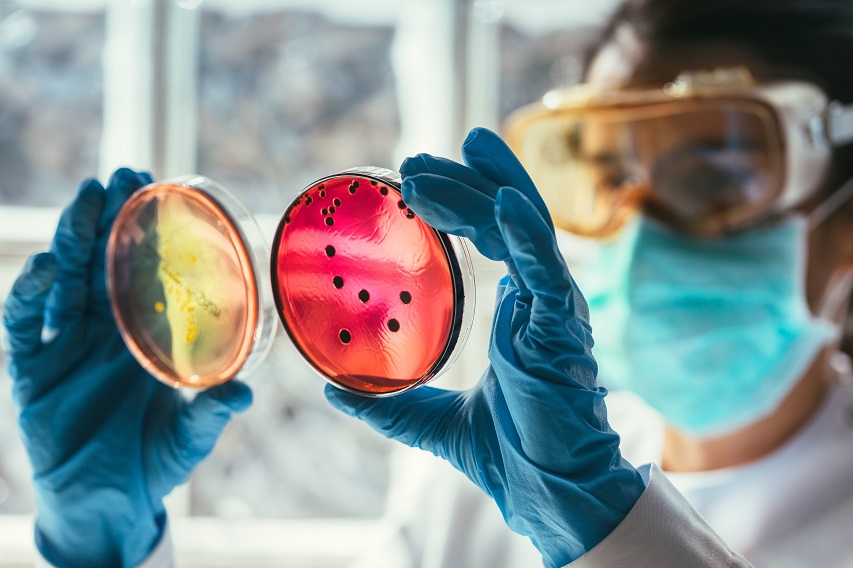

Antibiotikoekiko erresistentziek milioi heriotza baino gehiago eragiten dute urtero
16.11.2022

-
2019an 1,3 milioi heriotza eragin zituzten. Europan, 33.000 inguru, eta Estatuan, 3.000.
-
Antibiotikoak desegokiro erabiltzeak (tratamenduen posologia eta iraupen desegokiak) edo neurriz gain hartzeak (inork agindu gabe), areagotzen dituzte antibiotikoekiko multierresistentziak, pertsonengan nahiz animaliengan, baita antibiotikoak behar ez diren tokietan botatzeak ere –SIGRE botika-guneetara eraman behar dira beti.
Nazioarteko hainbat erakundek, hala nola Osasunaren Mundu Erakundeak (OME), Elikadura eta Nekazaritzarako Nazio Batuen Erakundeak (FAO), Nazio Batuen Ingurumen Programak (NBIP edo ingelesezko siglak: UNEP) eta Animalien Munduko Osasun Erakundeak (OMSA) argi dute: «Mikrobioen aurkako botikekiko erresistentzia mehatxua da gizakiontzat, animalientzat, landareentzat eta ingurumenarentzat. Guztioi eragiten digu. Mikrobioen aurkako botikekiko erresistentziaren kontrako borroka mundu-mailako ahalegina da eta, hortaz, One Health ikuspegitik ekin beharko zaio», adierazi dute erakundeok.
Mehatxu hori modu eraginkorrean geldiarazteko, erakundeek nabarmendu dute sektore guztiek ahaleginak batu behar dituztela eta mikrobioen aurkako botiken erabilera zuhurra eta prebentzio-neurriak sustatu. «Osasun-arreta ematen dituzten establezimenduetan, abeletxeetan eta elikagaien industriako instalazioetan infekzioen prebentzioa eta kontrola indartu behar dira; txertoak, ur garbia, saneamendua eta higienea eskura jartzea bermatu behar da; elikagaien ekoizpenean eta nekazaritzan jardunbide egokienak ezarri behar dira, eta industria nagusienetako hondakinen eta hondakin-uren kudeaketa egokia bermatu behar da, ekintza horiek guztiak funtsezkoak baitira mikrobioen aurkako botiken beharra murrizteko eta mikrobioen aurkako botikekiko erresistentzien agerpena eta transmisioa minimizatzeko».
‘Elkarrekin mikrobioen aurkako botikekiko erresistentziak prebenitzen’ mundu-mailako lelopean, IMQ Taldeak bat egin du, aurten ere, azaroaren 18an Antibiotikoak zuhurtziaz erabiltzeko Europako Eguna gogora ekartzeko ekimenarekin, ezinbestekoa baita herritarren eta ingurumenaren osasun orokorrarentzat ez ezik, pazienteen segurtasun klinikoarentzat ere.
IMQ-ko Barne Medikuntzako espezialista Iván Cachorro sendagileak azaldu duenez, «bakterioekiko erresistentzia da bakterioak ezabatzeko edo kontrolatzeko antibiotikoen efektuetara moldatzeko bakterioek duten gaitasuna. Bakterio batzuk berez dira antibiotiko batzuekiko erresistenteak (berezko erresistentzia), baina arazorik handiena hartutako erresistentzia da, bakterioek antibiotikoen eraginpean egotean garatzen dituzten aldaketen ondorioz gertatzen dena. Oro har, aldaketa genetikoak izaten dira (geneen mutazioak eta transferentziak), denboraren poderioz berez ager daitezkeenak, eta tratamenduen eraginkortasuna galtzea eta beste pertsona batzuengana hedatu eta kutsatzeko arriskua areagotzea baldintzatzen dutenak».
Mikrobioen kontrako botikekiko erresistentziek hil egiten dute
Gaixotasunak Prebenitu eta Kontrolatzeko Europako Zentroaren aburuz, urtero, 33.000 pertsona inguru hiltzen dira Europan (3.000 inguru, Espainian), bakterio erresistenteek eragindako ospitale-infekzioen eraginez. Antibiotikoak neurriz gain edo desegokiro erabiltzea da erresistentziak agertzearen kausa nagusienetako bat. 2019an, 1,3 milioi heriotza mikrobioen aurkako botikekiko erresistentziak eragin zituen zuzenean.
«Antibiotikoak neurriz gain erabiltzeak (inork agindu ez dituenean hartzea, automedikazioa, esaterako) edo desegokiro erabiltzeak (infekzio jakin baterako egokia ez den antibiotiko bat ematea, ordutegia edo agindutako dosia ez betetzea, edo tratamenduari uztea adierazitako iraupena bete baino lehen sintomak hobetu direla nabaritzean) areagotzen dituzte erresistentziak agertzea, pertsonengan nahiz animaliengan», zehaztu du Cahorro doktoreak.
«Batzuetan, beste gaixotasun baterako aldez aurretik errezetatutako antibiotiko bat erabili ohi da, sintomak antzekoak direnean, medikuarekin kontsultatu gabe; hala ere, mediku batek bakarrik zehatz dezake gaixotasunak tratamendu antibiotikoa behar duen. Tratamendua zorrotz betetzen ez bada eta bakterio guztiak ezabatzen ez badira, bizirik irauten dutenei eragingo die gutxien tratamenduak, eta, hortaz, denborarekin andui erresistenteak hautatzea ekarriko du», adierazi du IMQ-ko barne-medikuntzako medikuak.
Europako egungo egoera
Gaixotasunak Prebenitu eta Kontrolatzeko Europako Zentroaren azken datuen arabera, mikrobioen aurkako botiketiko erresistentzia-mailei dagokienez, Zentro horri jakinarazitako Escherichia coli-ren isolamenduen erdiak eta Klebsiella pneumoniae-ren isolamenduen herenak ziren gutxienez mikrobioen aurkako botika talde batekiko erresistenteak zaintzapean, eta maiz gertatzen zen aldi berean mikrobioen aurkako botika talde batzuekiko erresistentzia.
Botika karbapenemikoekiko erresistentzia ohikoa izan zen P. aeruginosa eta Acinetobacter espezietan. Halaber, joera gorakorra izan zen Europar Batasunean bankomizinarekiko erresistenteak diren E. faecium anduien ehunekoan; izan ere, 2016ko % 11,6tik 2020ko % 16,8ra igo zen.
Europako Zentroak azpimarratu duenez, azken lerroko antibiotikoekiko –hala nola bankomizina eta karbapenemikoen taldea– erresistentziak, «arazo handia izaten jarraitzen du. Antibiotiko horiek eraginkorrak ez direnean, tratamendu-aukera oso mugatuak daude, eta, beraz, ez dute egoera guztietan funtzionatzen, eta horrek, batzuetan, emaitza oso txarrak eragiten ditu. Azken lerroko antibiotikoekiko erresistentziak, halaber, arriskuan jartzen du biziak salbatzen dituzten tratamendu medikoen eraginkortasuna, hala nola minbiziaren kontrako tratamendua eta organoen transplantea».
Gomendioak
- Erabili antibiotikoak mediku batek (edo albaitari batek, animalien kasuan) agintzen baditu bakarrik, aldez aurretik infekzio diagnostikoa, tratamendu antibiotikoa behar duena, badago. Botika horiek bakterioek eragindako infekzioak tratatzeko bakarrik dira eraginkorrak. Ez dira eraginkorrak birusei aurre egiteko (esaterako, gripea, hotzeria edo COVID-19a eragiten dutenak) eta ez dituzte mina eta sukarra arintzen. Infekzio-motaren eta dagokion eremuko erresistentzia-ereduaren araberako antibiotiko egokiena aukeratuko da.
- Bete zorrotz medikuak agindutako tratamenduaren dosia eta iraupena.
- Eraman sobratu diren antibiotikoak botiketako bulegoetan dauden SIGRE guneetara, ondoren ontziak gaika bil daitezen eta botika-hondarrak prozesa daitezen. Ez gorde eta ez partekatu beste pertsona batzuekin.
- Garbitu maiz eskuak.
- Eduki elikagai-higiene egokia.
- Ez izan harreman zuzenik gaixoekin.
- Bete zorrotz txertoen egutegia.